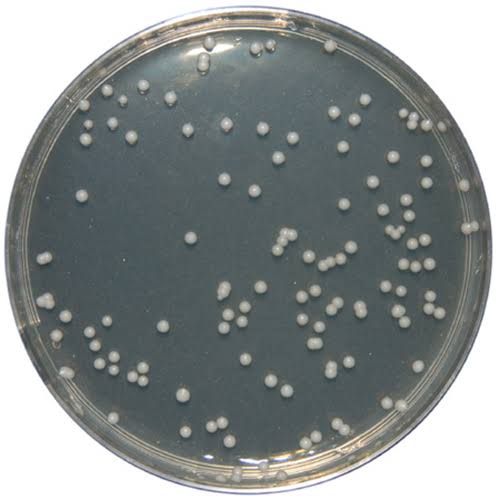

محیط کشتهای میکروبی یکی از پایههای اصلی آزمایشهای تشخیصی، تحقیقاتی و کنترل کیفی در صنایع دارویی و غذایی هستند. محیط کشت سابرو دکستروز آگار (Sabouraud Dextrose Agar – SDA) یکی از پرکاربردترین محیطهای کشت برای رشد قارچها و مخمرها محسوب میشود.
برند Merck (مرک) با ارائه سابرو دکستروز آگار با کد 105438، محصولی با کیفیت بالا و مطابق استانداردهای بینالمللی عرضه کرده است که توسط شرکت ایدهآوران طب پیشتاز بهصورت اصل و مستقیم در ایران تأمین میشود.
محیط کشت سابرو دکستروز آگار (SDA) چیست؟
Sabouraud Dextrose Agar (SDA) یک محیط کشت جامد، انتخابی و اسیدی است که بهطور ویژه برای کشت و جداسازی قارچها (Fungi)، مخمرها (Yeasts) و درماتوفیتها طراحی شده است.
pH اسیدی این محیط (حدود 5.6) باعث مهار رشد بسیاری از باکتریها شده و شرایط ایدهآلی برای رشد قارچها فراهم میکند.
ترکیبات اصلی محیط کشت سابرو دکستروز :
- Dextrose (دکستروز) : منبع انرژی برای رشد قارچها
- Peptone : منبع نیتروژن و اسیدهای آمینه
- Agar : عامل جامدکننده محیط
- pH اسیدی : جلوگیری از رشد باکتریها
کاربرد محیط کشت سابرو دکستروز:
تشخیص و جداسازی قارچهای بیماریزا
کشت مخمرها مانند Candida spp.
کنترل کیفی در صنایع دارویی و آرایشی
آزمایشگاههای میکروبیولوژی بالینی
تحقیقات دانشگاهی و پژوهشی
طرز تهیه محیط کشت سابرو دکستروز :
- مقدار مشخصی از پودر SDA را در آب مقطر حل کنید.
- حرارت دهید تا کاملاً حل شود.
- اتوکلاو در دمای 121°C به مدت 15 دقیقه
- خنکسازی و ریختن در پلیت یا لوله
⚠️ رعایت شرایط استریل الزامی است.

مزایای سابرو دکستروز مرک نسبت به سایر برندها :
- کیفیت ثابت و تکرارپذیر
- تطابق کامل با استانداردهای بینالمللی (ISO، USP)
- رشد یکنواخت و واضح کلونیها
- اطمینان از نتایج دقیق آزمایشگاهی

چرا خرید SDA مرک از ایدهآوران طب پیشتاز :
شرکت ایدهآوران طب پیشتاز بهعنوان تأمینکننده تخصصی مواد شیمیایی و محیطهای کشت آزمایشگاهی، مزایای زیر را ارائه میدهد:
خرید محیط کشت سابرو دکستروز آگار
- واردات مستقیم محصولات Merck
- تضمین اصالت کالا
- مشاوره تخصصی پیش از خرید
- ارسال سریع به سراسر کشور
- تأمین مواد مصرفی آزمایشگاهی و دارویی
جمع بندی :
محیط کشت سابرو دکستروز آگار (SDA) مرک کد105438 یک انتخاب ایدهآل برای کشت و شناسایی قارچها و مخمرها در آزمایشگاههای تشخیصی و تحقیقاتی است.
کیفیت بالا، استاندارد جهانی و تأمین مطمئن از طریق ایدهآوران طب پیشتاز، این محصول را به گزینهای قابل اعتماد تبدیل کرده است.
منابع :
- Merck KGaA, Sabouraud Dextrose Agar Product Information, Germany
- ISO 11133:2014 – Microbiology of food and animal feeding stuffs
- Clinical and Laboratory Standards Institute (CLSI), Microbiology Procedures
- Jawetz, Melnick & Adelberg’s Medical Microbiology, 28th Edition
دیدگاه خود را بنویسید